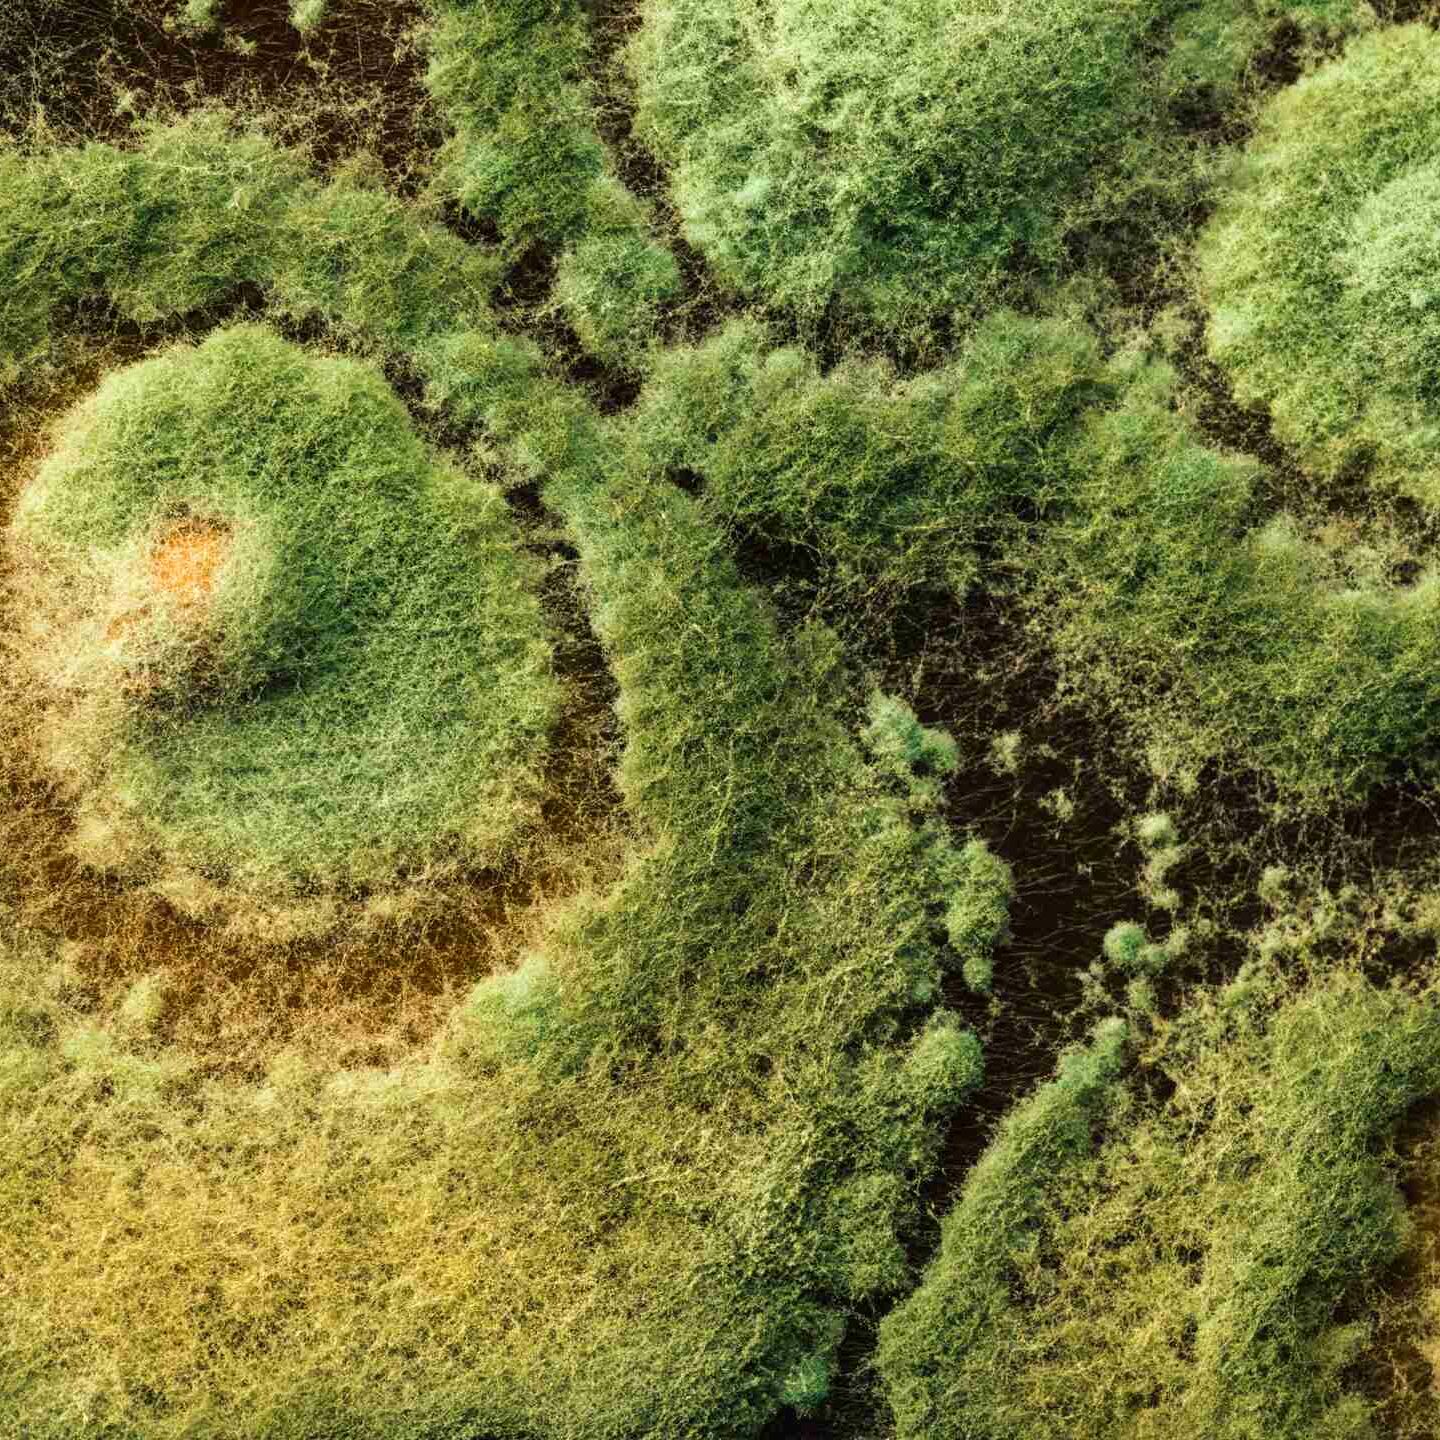

Aplicación
- Utilizar equipas específicos de tratamiento de semillas que permitan un recubrimiento uniforme de las mismas;
- Colocar un volumen conocido de semi nas en el interior dei equipo de tratamiento de seminas;
- Aiiadir los productos químicos ai equipo y realizar el tratamiento;
- Después dei tratamiento con los productos químicos, anadir TRICHODERMIL 1306 según las recomendaciones anteriores y agitar las semillas hasta que la cobertura sea uniforme;
- Almacenar las semillas ai sol hasta el momento de la siembra.
EI tiempo de agitación para el tratamiento de las semillas varia en función dei equipo utUizado, la cantidad de semillas y las dosis empleadas, debiendo mantenerse siempre la agitación hasta que las seminas queden perfectamente cubiertas.